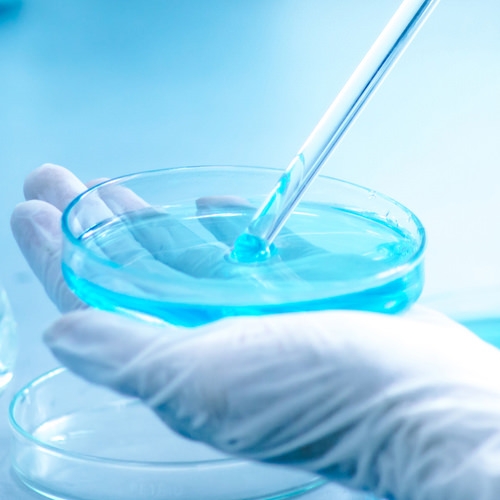

今までのスキンケアとは全く異なる次世代スキンケア【Step's CELL HOME CARE】
髪本来の美しさを取り戻す。サイタイ血から生まれた次世代スキンケア。

培養エキスは好配合50%と豊富に使用
ヒトの皮下脂肪から得られる幹細胞培養液は、美容の新しい革命的成分として徐々に認知度を高めています。
人間の細胞や幹細胞研究は近年研究が進み、新たなことが分かってきていますが、ヒト幹細胞培養液には有用成分が豊富に含まれ、健康をサポートできると考えられています。
幹細胞とは細胞の基となる細胞のことです。
自分と同じコピーを作ったり、どんな細胞にもなれる特徴を持っています。
ヒト幹細胞を培養するときに得られる「ヒト幹 細胞培養エキス」は、保湿因子や増殖因子などが豊富に含まれます。
「ヒトサイタイ血幹細胞シリーズ」は、この培養エキスを使用した化粧品です。
ヒト幹細胞培養エキスが美肌成分を後押し
培養液を豊富に含んだヒト幹細胞培養エキスは、コラーゲンやエラスチン、ヒアルロン酸などの美肌成分をサポート。
ハリや弾力を与え肌本来の美しさを高めます。
USC1994-EXS(ヒトサイタイ血由来幹細胞エクソソーム)
エクソソームは幹細胞から抽出され、細胞の再生などを行います。また、細胞間でメッセンジャーとして働き、弱った部分を強化します。医療により毛母細胞の再生、分化・増殖を促進し、髪の毛のボリューム増に適した環境を整えます。

ナイアシンアミド
ナイアシンアミドとは、シワなどの効果があるとして注目を集めるものです。最大の魅力は、角質層のバリア機能をサポートする働きから、肌との相性がとてもいいこと。肌質を問わず取り入れやすいため、年間を通して使用できるのも嬉しい特徴です。

ツボクサ葉/茎エキス
ツボクサ製品は、肌のバリア機能強化、、再生をサポートします。特に傷やニキビ跡に効果的で、コラーゲン合成をサポートし肌の弾力とハリをサポートします。アジアチコシドが線維芽細胞の増殖と移動をサポートし、マデカッソシドが細胞分化を調整します。

カンゾウ根エキス
カンゾウ根エキスのグラブリジンは色素の生成を抑え、白い肌への効果が期待されます。甘草の葉エキスは毛髪成長をサポートし、チロシナーゼ抑制でシミやくすみ防止にも良いです。

オタネニンジン根エキス
オタネニンジン根エキスにチロシナーゼ活性サポートによる抗白髪作用やコラーゲン産生サポートによる抗シワ作用が認められています。
Step's CELL HOME CARE

Step's CELL HOME CARE 50ml
販売価格:8,580円(税込)
今までのスキンケアとは全く異なる次世代スキンケア。エクソソームを豊富に含む、美容業界注目の成分である「幹細胞培養エキス」を贅沢に配合したヒトサイタイ血幹細胞シリーズ。 このヒトサイタイ血幹細胞培養エキスが肌の土台を快適な環境え、年令を重ねても美しい肌に導きます。